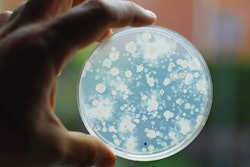

As of October 1, hunters in Victoria, Australia could start harvesting 14,090 kangaroos for as a novel pet food protein. The Victoria state government started the Kangaroo Harvesting Program to reduce the population of native kangaroos. Agriculture Victoria’s website states that the reasons for the hunt are that the kangaroos eat human crops, drink water designated for livestock and damage fences and other property. The quota of kangaroos can be harvested until the end of this year, when new quotas will be established by the state government.
Details of kangaroo harvesting for pet food
Victoria’s Department of Jobs, Precincts and Regions in collaboration with the Game Management Authority will manage the harvest and use in pet food. The meat is not approved for human consumption, so the processors will prepare it for use in pet food. Only specially authorized hunters can harvest the marsupials. Those harvesters must have taken courses covering firearms proficiency and wild game skills.
Specific numbers of kangaroos can be hunted in different regions of Victoria. Three processing companies, Yering, Stanhope and Hamilton, are authorized to handle the kangaroo carcasses, though others may join. Any pet food processor licensed by PrimeSafe can receive kangaroo carcasses.
In 2014, a two-year trial in Victoria started to study the feasibility of kangaroo meat as a novel pet food ingredient, involving eastern and western grey kangaroos.
Within the past few decades, pet food manufacturers’ options for providing protein in their products have grown dramatically. Just as people have come to embrace a wider variety of animal and plant proteins on their plates, so too have pet owners started serving non-traditional meats and plants to their dogs and cats. Once unheard of ingredients, including kangaroo, hemp and insects have all found their way into pets’ dishes.